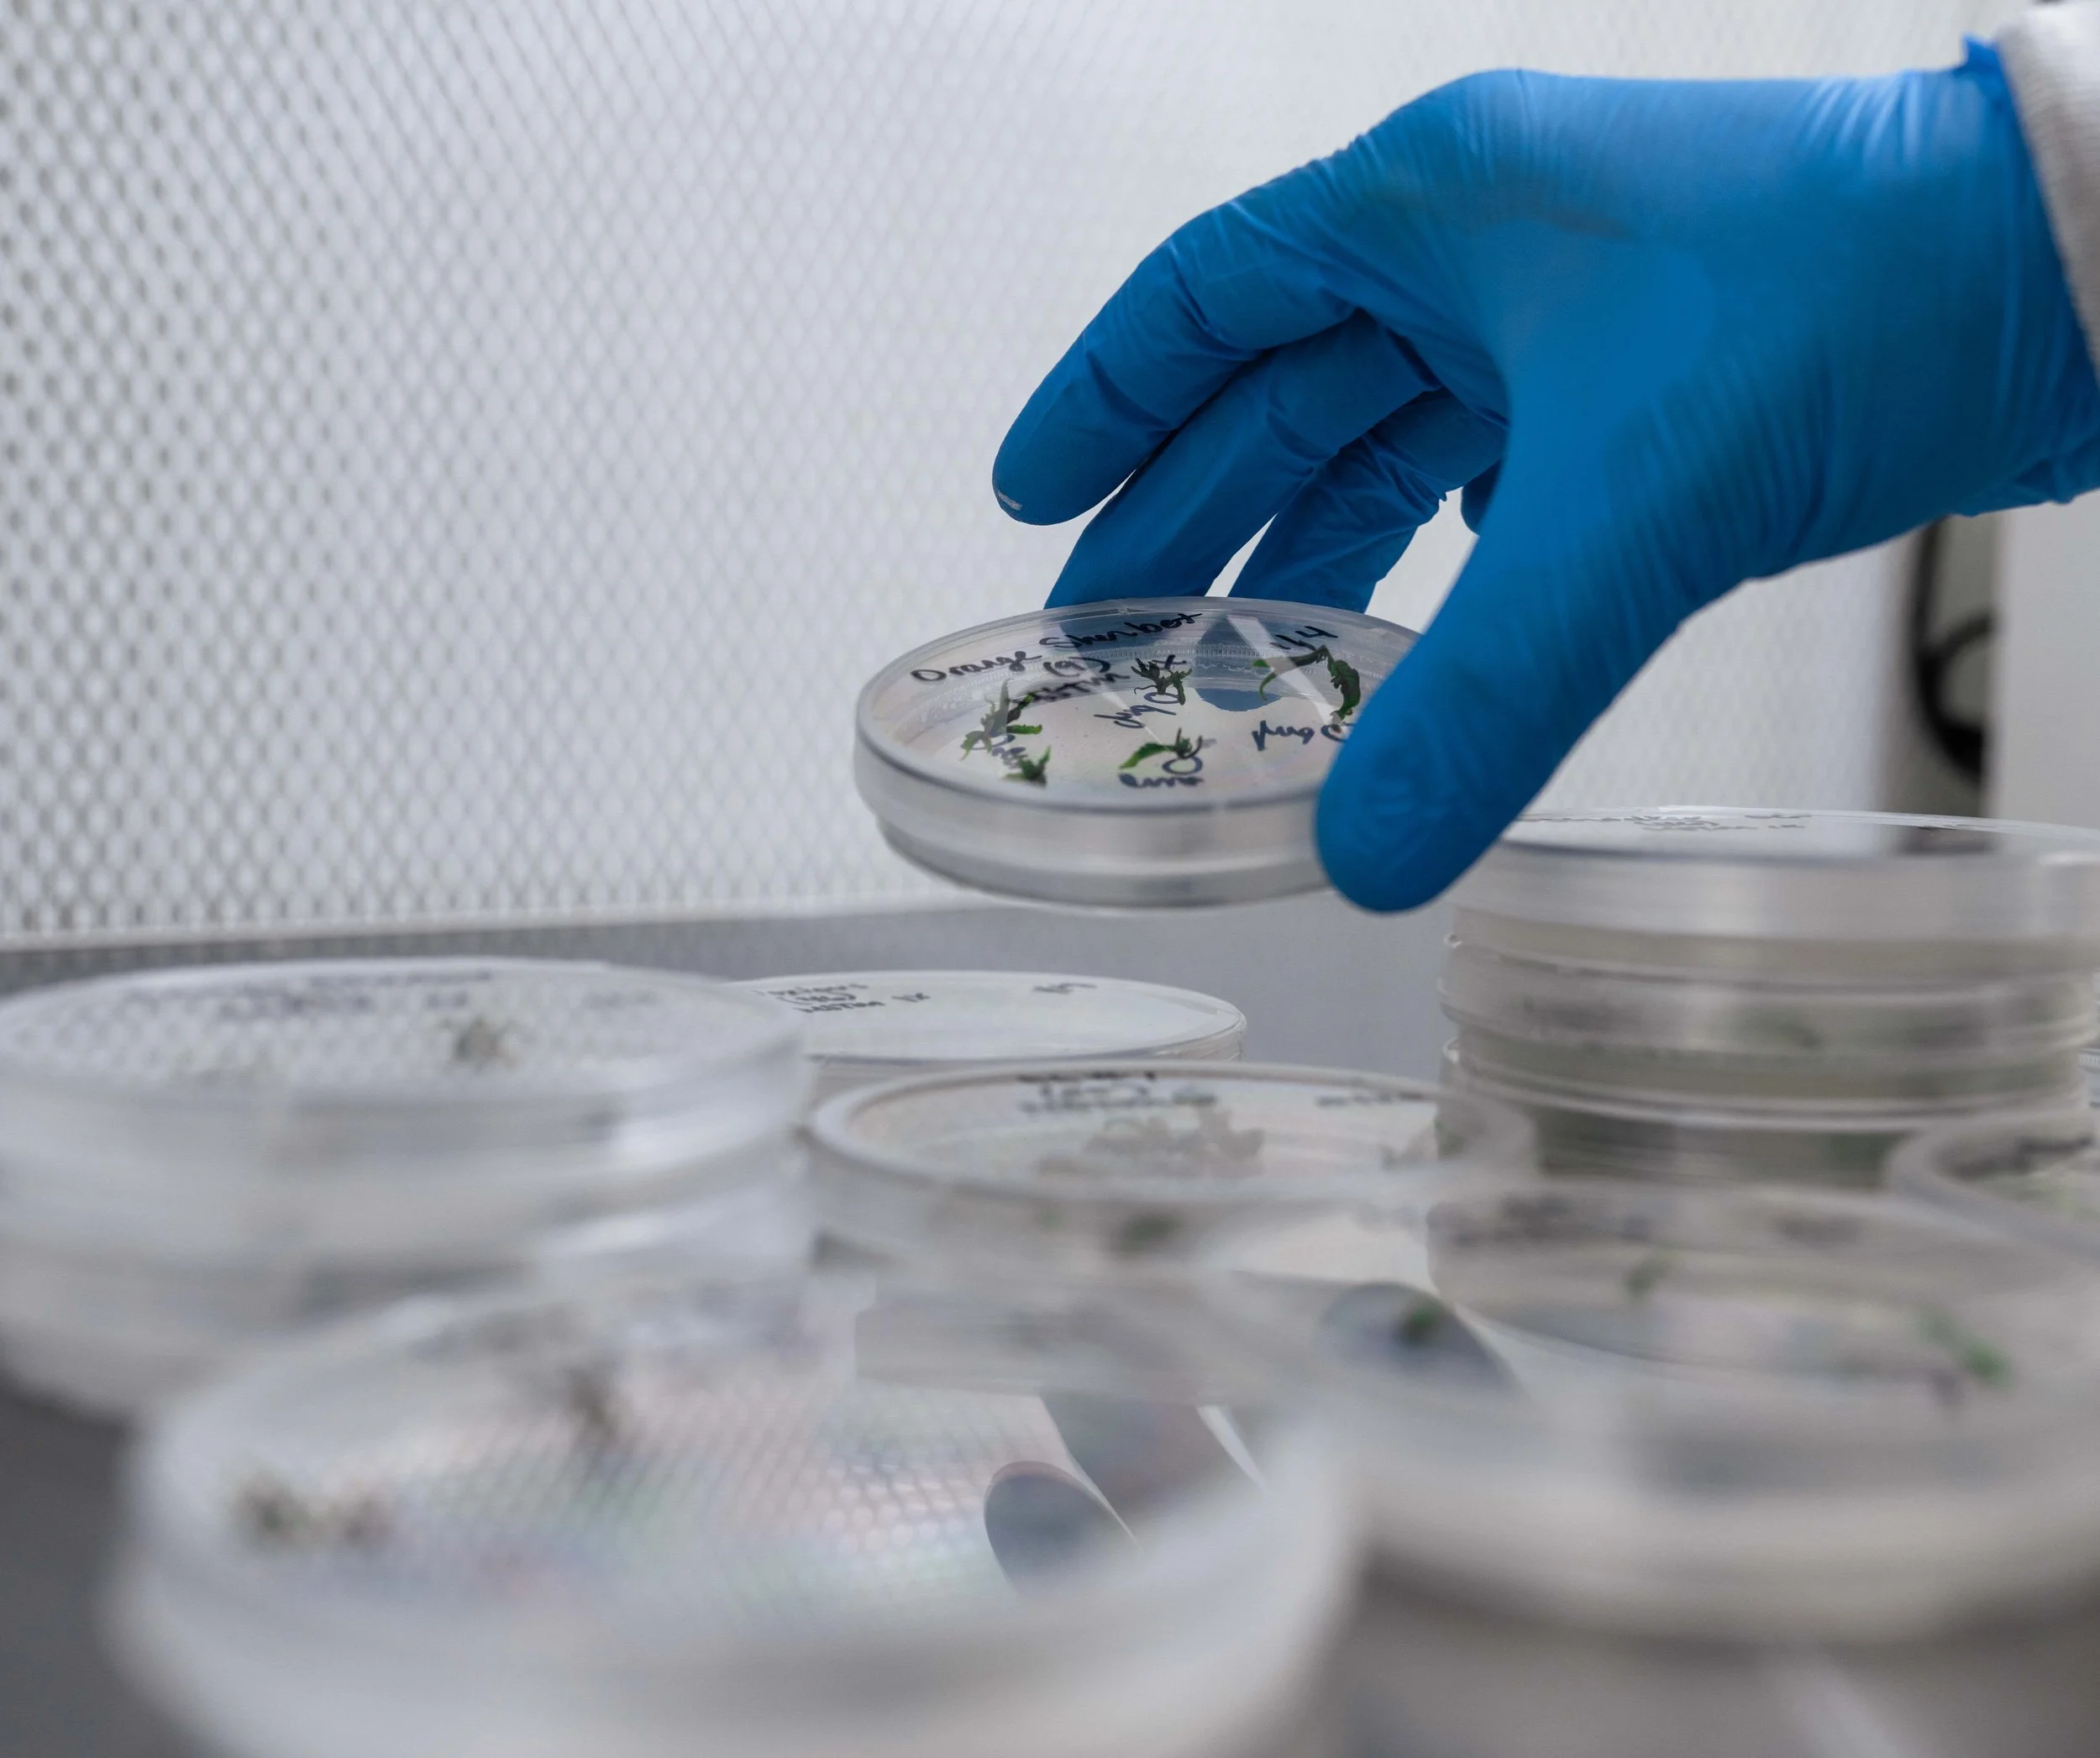

TECHNOLOGY
A Robust Portfolio of IP-Protected Technology Assets
Across our many businesses, GCI places a premium on developing and protecting technology as well as process-based intellectual property. Today, our technology portfolio is at the core of what makes GCI one of the most valuable integrated companies in cannabis. Notable technologies include:

Tissue culture nutrient recipes and multiplication technologies. Please visit Phinest Tissue Culture Lab for more.
Tissue culture bacteria, virus, and viroid eradication technology. See Phinest Tissue Culture Lab for info.

Mother plant nutrients, crop-steering techniques and environmental strategies
Cloning nutrients and sensor-data-based environmental strategies
Clone growth, acceleration/deceleration, life-extension and metabolic enhancement technologies and strategies
Cultivation nutrients, environmental modification technologies and crop-steering strategies

Irrigation strategies and proprietary technology applications
Integrated Pest Management (IPM) formulas, treatments and technologies
Proprietary sales operations and data management platform
Proprietary nursery operations software platform

